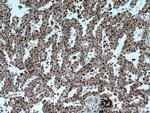
GMFG Antibody in Immunohistochemistry (Paraffin) (IHC (P))

Search
Proteintech
GMFG Polyclonal Antibody
{{$productOrderCtrl.translations['antibody.pdp.commerceCard.promotion.promotions']}}
{{$productOrderCtrl.translations['antibody.pdp.commerceCard.promotion.viewpromo']}}
{{$productOrderCtrl.translations['antibody.pdp.commerceCard.promotion.promocode']}}: {{promo.promoCode}} {{promo.promoTitle}} {{promo.promoDescription}}. {{$productOrderCtrl.translations['antibody.pdp.commerceCard.promotion.learnmore']}}
产品信息
13625-1-AP
种属反应
已发表种属
宿主/亚型
分类
类型
抗原
偶联物
形式
浓度
规格
纯化类型
保存液
内含物
保存条件
运输条件
产品详细信息
Immunogen sequence: SDSLVVCEV DPELTEKLRK FRFRKETDNA AIIMKVDKDR QMVVLEEEFQ NISPEELKME LPERQPRFVV YSYKYVHDDG RVSYPLCFIF SSPVGCKPEQ QMMYAGSKNR LVQTAELTKV FEIRTTDDLT EAWLQEKLSF FR (1-141 aa encoded by BC032819)
靶标信息
Glia maturation factor gamma (GMFG) is a cytokine-responsive protein in erythropoietin-induced and granulocyte-colony stimulating factor-induced hematopoietic lineage development. It may be involved in glial differentiation, neural regeneration, and inhibition of tumor cell proliferation.
仅用于科研。不用于诊断过程。未经明确授权不得转售。
生物信息学
蛋白别名: Glia maturation factor gamma; GMF-gamma; GMFG
基因别名: 0610039G16Rik; 2310057N07Rik; AI324845; GMF-GAMMA; GMFG
UniProt ID: (Human) O60234, (Rat) Q80T18, (Mouse) Q9ERL7
Entrez Gene ID: (Human) 9535, (Rat) 113940, (Mouse) 63986